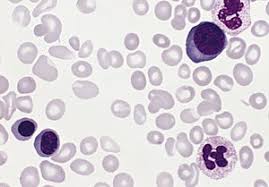
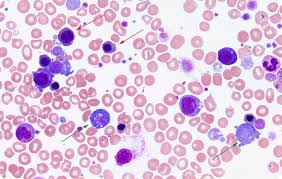

Porphyrins are a group of compounds defined by their chemical structure. These compounds are by-products of heme synthesis and are normally present at low concentrations in blood and other body fluids. Porphyrin tests measure porphyrins and their precursors in urine, blood, and/or stool.
Heme is an iron-containing pigment that is a component of hemoglobin and a number of other proteins. It consists of an organic portion (protoporphyrin) bound to an iron atom. The synthesis of heme is a step-by-step process that requires the sequential action of eight different enzymes. If there is a deficiency in one of these enzymes, the process is impeded and intermediate porphyrins such as uroporphyrin, coproporphyrin, and protoporphyrin build up in the body's fluids and tissues. The precursors that accumulate depend on which enzyme is deficient, and they can exert toxic effects.
Porphyrin tests are used to help diagnose and monitor a group of disorders called porphyrias. There are seven types of porphyria, and each one is associated with a different enzyme deficiency. Most porphyrias are inherited, the result of a gene mutation. They may be classified according to the signs and symptoms of the disease as neurological, cutaneous, or both.
The porphyrias that cause neurological symptoms present with acute attacks lasting days or weeks. Signs and symptoms during the attack include abdominal pain, constipation, confusion, hallucinations, and/or seizures. There are four neurologic porphyrias: acute intermittent porphyria (AIP), variegate porphyria (VP), hereditary coproporphyria (HCP), and the very rare ALA dehydratase deficiency porphyria (ADP). Some cases of VP and HCP may also have skin-related symptoms.
The cutaneous porphyrias are associated with photosensitivity that causes redness, swelling, a burning sensation, blistering, skin thickening, hyperpigmentation, and/or scarring. There are three cutaneous porphyrias: porphyria cutanea tarda (PCT), erythropoietic protoporphyria (EPP), and congenital erythropoietic porphyria (CEP). For more information about each disease, see the article on Porphyria.
To diagnose porphyrias, clinical laboratories measure porphyrins and their precursors in urine, blood, and/or stool. Testing may include measurement of one or more of the following:
1.Porphobilinogen (PBG), a porphyrin precursor, in urine
2.Delta-aminolevulinic acid (ALA), another porphyrin precursor, in urine
3.Porphyrins (uroporphyrin, coproporphyrin, and protoporphyrin) in urine, blood, or stool
Specialized laboratories may offer testing for one or more of the affected enzymes. The most commonly measured enzyme is porphobilinogen deaminase (PBG-D) in red blood cells, which tests for acute intermittent porphyria. A few laboratories offer genetic testing for specific gene mutations that cause one of the porphyrias, but this type of testing is not widely available.


 Contact Us
Contact Us






 Hospitals
Hospitals
 Doctors
Doctors
 Diagnostic
Diagnostic
 Pharmacy
Pharmacy
 Health Tips
Health Tips
 Blog
Blog